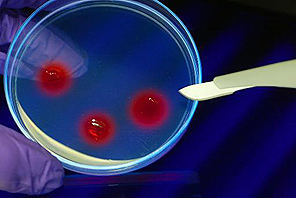

This edition was published on 11/16/09 at 1:42 a.m.
[ Go to the front page ]
|
||||||||||||||||||||||||||||||||||||||||||||||||||||||||||||||||||||||||||||||||||||||||||||||||||||||||||
|
|
|||||||||||||||||||||||||||||||||||||||||||||||||||||||||||||||||||||||||||||||||||||||||||||||||||||||||
|
Connect with us:
|
||||
|
||||

|
Copyright © 2006-2024 The Daily Source. All rights reserved. Terms of Service
Website monitoring for The Daily Source provided for free by Nimsoft